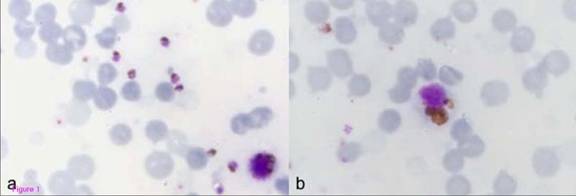

Mặc dù có những cuộc nghiên cứu mang tầm quốc tế được tiến hành khẩn trương trong nhiều năm qua, người ta vẫn chưa hiểu rõ một cách đầy đủ về cơ chế sinh lý truyền bệnh sốt rét. Những nghiên cứu này không nhằm ngoài mục đích là làm giảm tác động của KSTSR Plasmodium falciparum đối với tính mạng con người, đặc biệt đối với trẻ em sống tại lục địa châu Phi [1,2]. Một trong những khó khăn khi nghiên cứu cơ chế sinh bệnh của P. falciparum là chưa thể xác định được mối quan hệ giữa động vật với căn bệnh tương ứng trên cơ thể người. Với những khám phá gần đây về SR ác tính gây ra do loài KSTSR Plasmodium knowlesi ký sinh ở động vật tại một số quần thể dân cư Đông Nam Á [3, 4], giờ đây người ta có thể hiểu được mối quan hệ bệnh tật giữa các loài linh trưởng và con người qua mầm bệnh chung này.
Khi sống trong cơ thể vật chủ tự nhiên là loài linh trưởng (khỉ đuôi dài có tên khoa học là Macaca mulatta sống tập trung tại các nước trong khu vực Đông Nam Á), KSTSR P.knowlesi không gây những triệu chứng của bệnh SR hoặc nếu có là những triệu chứng ở mức độ nhẹ. Tuy nhiên, chúng lại gây những triệu chứng ác tính và thậm chí tử vong khi được gây nhiễm trên loài khỉ Rhesus thường được sử dụng trong labô thí nghiệm [5]. Qua đó, người ta có thể hiểu biết nhiều hơn về SR do P.knowlesi gây ra qua các thử nghiệm tại labô, kể cả quá trình sinh bệnh ở nhiều cơ quan khác nhau trên có thể động vật [6-8]. Trước đây, hiện tượng nhiễm KSTSR P.knowlesi ở người thường bị bỏ sót do loài này có hình thái tương đồng với KSTSR Plasmodium malariae ở người [9, 10]. Giờ đây, người ta có thể biết được tường tận những triệu chứng lâm sàng của bệnh SR do P.knowlesi, từ mức độ SR thường đến biến chứng nặng và có thể gây tử vong [3, 4].
 |
Macaca mulatta, loài khỉ đuôi dài sống tập trung tại các nước trong khu vực Đông Nam Á
được xem là có khả năng truyền KSTSR P. knowlesi sang người với những biến chứng
ác tính và tử vong. |
Cơ chế sinh bệnh trong SR ác tính do KSTSR P.knowlesi cho đến nay vẫn chưa được giải thích cụ thể, nhưng nó lại quan trọng do những nguyên nhân chính. Thứ nhất, nó giúp cải thiện các hướng dẫn chẩn đóan, điều trị và quản lý các ca SR ác tính do P.knowlesi gây nên. Thứ hai, khi những ca SR ác tính do nhiễm P.knowlesi được so sánh với các ca SR ác tính do P.falciparum, điều này có thể giúp phân biệt các yếu tố gây mức độ ác tính của bệnh SR. Thứ ba, chúng ta có thể theo dõi quá trình dịch chuyển nhanh chóng từ vật chủ là động vật có xương sống (khỉ đuôi dài Đông Nam Á) sang quần thể người [11,12]. Do đó, điều quan trọng là chúng ta phải hiểu một cách đầy đủ về bệnh SR do KSTSR P. knowlesi để giúp đưa ra những biện pháp nhằm làm giảm những gánh nặng về sức khỏe một khi cơ chế lan truyền từ người sang người của loài KSTSR này là có thật.
Những kết quả về lâm sàng, cận lâm sàng và, lần đầu tiên- khám nghiệm mô bệnh học của một ca tử vong do KSTSR P.knowlesi được đề cập dưới đây. Quá trình sinh bệnh của các cơ quan khác nhau được giải thích cặn kẻ dựa trên các đặc tính sinh học của P.knowlesi và so sánh với những đặc điểm nổi bật của quá trình sinh bệnh SR ác tính do P.falciparum [13-16].
Mô tả ca bệnh
Bệnh sử và thăm khám
Một bệnh nhân nam, 40 tuổi được đưa vào Bệnh viện Queen Elizabeth Hospital, KotaKinabalu, Sabah lúc 8h30 sáng trong tình trạng suy sụp. Bệnh nhân không thể mô tả các triệu chứng của bệnh, cũng như không thể tự đứng lên được. Khi thăm khám, không đo được huyết áp và nồng độ Oxy bão hòa thấp. Không có tiền sử mắc bệnh SR, bệnh nhân đi vào khu rừng già Borneo (Indonesia) và ở đó 2 tuần trước khi về lại thành thị. Sau đó 10 ngày bệnh nhân cảm thấy sốt và đau khắp người. Hai ngày sau đó, ông ta đến phòng khám ngoại trú của nhà nước để được điều trị với các triệu chứng sốt và đau nhức vẫn còn tiếp diễn. Tại đây, người ta chỉ khám qua loa và ông có thể đi làm được dù có phát ban ngày hôm sau đó. Hai ngày sau ông vẫn cảm thấy không khỏe, lúc này ông có dấu hiệu suy sụp và đau bụng.
Bệnh nhân được điều trị cấp cứu hồi sức bằng thông khí quản với adrenaline/atropine và sodium bicarbonate. Thăm khám sau cấp cứu hồi sức, các dấu hiệu sinh tồn như sau: nhịp phổi BP 58/44 mm Hg, nhịp tim 40-50 lần/phút với mạch ngoại biên yếu và da xanh tím. Tiếng tim nghe bình thường. Trên cơ thể bệnh nhân xuất hiện các đốm xuất huyết, bụng bệnh nhân căng cứng.
Khi tiếp tục hồi sức trong một giờ nữa, phát hiện thấy “chất cặn màu cà phê” trong ống sonde dạ dày của bệnh nhân. Sau một giờ nữa, huyết áp tâm thu không nghe được, và dù được hồi sức thêm 20 phút nữa, cũng không có đáp ứng. Bệnh nhân được kết luận đã chết sau hai giờ nhập viện.
Lúc đó, hội chứng sốc do sốt xuất huyết được nghĩ tới và cuộc khám nghiệm tử thi được thực hiện khoảng 24 giờ sau khi bệnh nhân tử vong.
Kết quả cận lâm sàng
Các kết quả xét nghiệm được trình bày tóm tắt trong Bảng 1.
Bảng 1: Kết quả xét nghiệm lúc nhập viện |
 |
Bệnh nhân không thiếu máu, nhưng tiểu cầu giảm và tăng bạch cầu ái toan. Natri huyết giảm; các giá trị Urê huyết, Kali huyết, lactate dehydrogenase và amino transferase tăng. Soi lam máu lấy sau 24 giờ thấy trên 10% hồng cầu nhiễm KSTSR (Hình 1a). Cũng xuất hiện nhiều bạch cầu đơn nhân với nhiều sắc tố (Hình 1b). Kỹ thuật nested-PCR phát hiện chỉ một loài KSTSR Plasmodium knowlesi [9]. Xét nghiệm huyết thanh học về sốt xuất huyết cho kết quả âm tính (Bảng 1) và virus gây sốt xuất huyết, virus hợp bào ở phổi cũng như enterovirus không xuất hiện trên các mẫu mô phân lập.
|
Hình 1: Giọt đàn cho thấy các thể tư dưỡng trưởng thành của P. knowlesi trong hồng cầu bị ký sinh (1b)
và bạch cầu đơn nhân có sắc tố dày đặc (1b). Đây là lam máu được lấy sau 24 giờ kể từ bệnh nhân tử vong
nên có vài hồng cầu giả nằm xen kẻ với các hồng cầu bị nhiễm KSTSR |
Khám nghiệm tử thi
Bệnh nhân là người lớn, có tầm vóc cao to. Da vàng nhợt nhạt và mắt phải xuất huyết. Trên cơ thể cũng có vài đốm xuất huyết dưới da, các điểm tiêm tĩnh mạch xuất hiện vết thâm tím rõ ràng. Các chất dịch màu nâu xuất hiện ở miệng. Khám nội tạng không thấy phù mô hoặc dịch tiết ở các khoang cơ thể.
Mô tả lâm sàng bệnh học tổng thể
Bề mặt não có màu bả trầu. Các mẫu sin thiết xuất hiện đốm xuất huyết đa dạng. Ở vùng tiểu não cũng xuất hiện các đốm xuất huyết, kể cả trên các vết cắt. (hình 2a và 2b). Cuống não và đoạn trên của tủy sống tương đối bình thường. Cả 2 phổi nặng hơn bình thường (phối phải 720gr và phổi trái 690 gr), với mặt cắt bị sung huyết và co cứng lại. Các đốm xuất huyết cũng xuất hiện ở màng trong tim, đặc biệt các điểm xuất huyết ở dưới màng trong tim lan ra cả thành tâm thất trái. Ở mỏm tim, xuất huyết xuất hiện dày đặt. Gan và lách sưng to, nặng lần lượt tới 2.640gr và 340gr. Mặt cắt của lách mềm và dễ vỡ. Túi mật, tụy và thận bình thường.
 |
Hình 2:Hình ảnh tổng thể của bộ não. Bề mặt ngoài tối màu với các đốm xuất huyết có thể nhìn
thấy được trên thân não (2a). Mặt cắt thân não với nhiều đốm xuất huyết (2b) |
Mô tả lâm sàng bệnh học vi thể
Các mẫu sinh thiết của cơ quan khác nhau được cho nhuộm haematoxylin và eosintrước khi tiến hành các xét nghiệm cận lâm sàng.
Nhiều tế bào hồng cầu bị nhiễm KSTSR dù các hình thể của KST bị bao phủ bới các sắc tố haemozoin (loại sắc tố từ các mãnh vở hồng cầu do KSTSR thâm nhập). Bằng phương pháp loại bỏ các hạt sắc tố bằng hóa chất và soi dưới vật kính dầu (x 1.000 lần), các KSTSR ở thể tư dưỡng có kích thước to hơn hẳn so với KSTSR ở thể tư dưỡng của P. falciparum.
Kết quả xét nghiệm hóa miễn dịch tế bào cho thấy dương tính với kháng thể kháng enzyme aldolase của KSTSR (hình 3) và âm tính với kháng thể đặt hiệu của KSTSR P.falciparum [17] .
 |
Hình 3: Hình ảnh phần não được nhuộm để làm thử nghiệm hóa miễn dịch tế bào
với kháng thể đặc hiệu kháng enzyme aldolase của KSTSR. KSTSR hiện diện trên vi trường. |
Nhiều điểm xuất huyết ngoại biên (đường kính lớn nhất khỏang 600µm) xuất hiện ở các mao mạch thuộc vùng não và tiểu não (hình 4a và 4b). Hiện tượng đóng quánh các tế bào hồng cầu nhiễm KSTSR xuất hiện rõ ở các mao mạch (hình 4c và 4d). Ở những mạch máu lớn hơn và những điểm xuất huyết xuất hiện nhiều sắc tố của KSTSR (hình 4e và 4f). Không có hiện tượng huyết khối hoặc tắt mạch, cũng như không có dấu vết của hiện tượng viêm mạch hoặc viêm mạch ngoại biên mãn tính ở não và các cơ quan khác được khám nghiệm như tim, thận, gan, tuyến thượng thận hoặc lách.
 |
Hình 4: Những mặt cắt thân não được nhuộm bằng haematoxylin (a,b, c,e,f) và thân não (d).
Nhìn từ độ phóng đại nhỏ (20 lần) thấy các điểm xuất huyết trong phần xám và phần trắng (4a).
Xuất huyết ở lớp phân tử của tiểu não ở độ phóng đại 40 lần (4b). Các hình 4c (400 lần) và 4d (200 lần)
cho thấy các mao mạch với các tế bào hồng cầu nhiễm KSTSR dày đặt. Không có hiện tượng viêm
nhiễm hay tắt mạch ngoại biên. Tĩnh mạch nhỏ với các tế bào hồng cầu nhiễm KSTSR ở
độ phóng đại 200 lần (4e) và điểm xuất huyết cho thấy các hồng cầu nhiễm KSTSR xen lẫn
với các hồng cầu lành lặn ở độ phóng đại 400 lần (4f). |
Hiện tượng phù mạch ngoại biên và phù nhu mô não rãi rác cũng không xuât hiện. Không xuất hiện viêm thần kinh sao và thần kinh đệm rãi rác, cũng như không có hiện tượng u thần kinh đệm ác tính do xuất huyết. Không có tập trung của các bạch cầu đa nhân trung tính ở các mạch máu, không có hiện tượng viêm mạch ngoại biên cũng như không có hiện tượng viêm não tổng quát. Không có hiện tượng viêm tắt mao mạch, nhưng tại một điểm xuất huyết có xuất hiện các sợi huyết trên thành mạch máu. Xét nghiệm hóa miễn dịch tế bào một số nhu mô não thấy âm tính với CD54 (nhuộm bằng phân tử kết dính gian bào 1, ICAM-1).
Mặc dù một số mô lách có hiện tượng tử phân hủy, hiện tượng phình rộng của phần tủy đỏ và teo lại của phần tủy trắng cũng được nhận biết dễ dàng. Không xuất hiện các hạch mầm, nhưng lại có nhiều đại thực bào có chứa sắc tố và hiện tượng thực bào ở trong tủy đỏ, cộng với nhiều tế bào hồng cầu nhiễm KSTSR (hình 5a). Không có hiện tượng hoại tử và sợi huyết biến dạng ở các mô lách.  |
Hình 5: Các mô cơ quan được nhuộm bằng haematoxylin và eosin (5a) mô lách (ở độ phóng đại 400 lần) cho thấy các đại thực bào phần tủy đỏ chứa nhiều sắc tố KSTSR và hình ảnh các tế bào hồng cầu bị nuốt. (5b) mô gan (x 400 lần) cho thấy các túi mỡ lớn của các tế bào gan tuy không phải là chứng gan nhiễm mỡ. Các rãnh ngoằn ngoèo cho thấy các tế bào hồng cầu nhiễm đầy KSTSR cũng nhưng các tế bào Kupffer chứa các sắc tố sắt. (5c) mô thận (x 200 lần) cho thấy hiện tượng hoại ác tính các tiểu quản cùng với những khối tế bào chết trong các tiểu quản. Bên trong tĩnh mạch thận cũng xúât hiện các tế bào hồng cầu nhiễm KSTSR Các sợi cơ ở tâm thất trái tim bình thường ở độ phóng đại 200 lần (5d). Các tĩnh mạch nhỏ và mao mạch với hồng cầu chứa đầy KSTSR và các tế bào màng trong tim chiếm ưu thế. |
Có nhiều hồng cầu nhiễm KSTSR ở các võng huyết quản ở gan cùng với các hạt sắc tố trong các tến bào Kupffer và có hiện tượng thực bào. Các mạch máu chính và các võng huyết quản ở gan cũng có hiện tượng viêm tế bào lymphô mãn tính. Nhìn chung, bệnh nhân không bị xơ gan, nhưng gan bị nhiễm mỡ nặng. Không có hiện tượng tắt mật, nhưng xảy ra hoại tử cục bộ và viêm tắt mao mạch (hình 5b).
Bề mặt thận cho thấy các mạch máu bị giãn nở và viêm tắt. Nhiều hồng cầu nhiễm KSTSR xuất hiện ở các mao quản tiểu cầu thận với nhiều sắc tố ở màng treo. Không có viêm tắt mao mạch thận, nhưng xảy ra hiện tượng hoại tử ác tính các tiểu quản cùng với xuất hiện lác đác hiện tượng tăng bạch cầu ưa acid ở các rãnh tiểu quản (hình 5c).
Tại các mạch máu nhỏ ở tim cũng xảy ra viêm tắt do các tế bào hồng cầu nhiễm KSTSR (hình 5d). Ở những bệnh nhân bị nhiễm trùng, các tế bào màng trong tim thường xuất hiện nhiều do phản ứng với các chất ngoại sinh [18]. Không có hiện tượng viêm cơ tim và các tế bào cơ tim bình thường. Xuất hiện rãi rác các đốm xuất huyết ở dưới màng trong tim, có thể liên quan tới việc hô hấp nhân tạo, hoặc có thể do bệnh sốt rét.
Ở tuyến thượng thận, các tế bào ưa acid tăng tại các lớp tủy và không có hiện tượng viêm tắt do hồng cầu nhiễm KSTSR tại các điểm xuất huyêt nhu mô. Các mẫu tế bào phổi, ruột và tủy xương không có trong khám nghiệm mô bệnh học.
Bức tranh tổng thể trên là một ví dụ có hệ thống của một ca nhiễm KSTSR với nhiều nhiều phủ tạng bị ảnh hưởng, đặc biệt là ở não với nhiều mạch máu bị vỡ và xuất hiện nhiều đốm xuất huyết.
Kết luận
Cho đến nay, chưa có báo cáo nào mô tả bệnh sốt rét do P.knowlesi qua khám nghiệm tử thi, do đó bài viết này nhằm mục đích làm sáng tỏ hơn về loại SR gây biến chứng nặng và tử vong do các hội chứng ở các cơ quan phủ tạng. Một điều khá lý thú là hiện nay, bệnh SR do P.vivax cũng đôi khi được xem là có thể gây SRAT ở một vài ca bệnh. Điều nay buộc người ta phải xem xét lại nhận định từ trước đến giờ chỉ có P.falciparum mới có thể gây SRAT và tử vong [19-21].
Việc phân loại SRAT do P.falciparum của Tổ chức Y tế thế giới (WHO) nên bao gồm trường hợp tử vong này vì ông ta có các triệu chứng phân loại cụ thể như tăng KSTSR (khoảng 10% hồng cầu nhiễm KSTSR), suy thận, vàng da và hội chứng suy phổi cấp (ARDS), dù bệnh án không ghi nhận hiện tượng hôn mê ở bênh nhân này [3, 4, 22]. Nhìn chung, bệnh sốt xuất huyết dengue (DHF) cũng có thể gây nên các triệu chứng ác tính đe dọa đến tính mạng bệnh nhân như thế này, nhưng các thăm khám không đề cập tới. Khả năng nhiễm phối hợp 2 loại KSTSR P.knowlesi và P.falciparum cũng không được tính đến trong xét nghiệm hóa miễn dịch tế bào và PCR đặc hiệu.
Hình ảnh các mô phổi phù to trong ca bệnh này trùng khớp với những mô tả về hội chứng suy hô hấp cấp, nhưng không được mô tả trước đó trong bệnh án. Những thay đổi ở thận tại các vùng hồi phục sau chấn thương tiểu quản ác tính cũng trùng khớp với những quan sát ở các bệnh nhân suy thận khác nhiễm KSTSR P.knowlesi [3], và sự hoại tử các ống tiểu quản có liên quan tới hội chứng sốc hệ thống. Những vùng tủy trắng không phân bố đều ở lách có lẽ là một phần do phản ứng sốc lan rộng [18].
Mặc dù không có tiên lượng về hôn mê, các bệnh lý về não trong ca SR này hầu như trùng khớp với những triệu chứng thường gặp ở các bệnh nhân tử vong do SR falciparum, cho thấy điều quan trọng là loại trừ hiện tượng nhiễm phối hợp giữa 2 loài KSTSR. Mặc dù cũng có sự viêm tắt các tế bào hồng cầu nhiễm KSTSR ở các mao quản và mạch máu, còn tồn tại một vài điểm khác biệt với những hiện tượng viêm tắt trong các ca tử vong do nhiễm P.falciparum. Ví dụ, không có hiện tượng kết dính tiểu cầu, hoặc nghẽn mạch nếu có cũng không đáng kể, đặc biệt các tế bào hồng cầu lành lặn không kết dính với các tế bào nhiễm KSTSR. Ở các tế bào nội màng, không có phản ứng dương tính với phân tử kết dính gian bào 1, ICAM-1, cho thấy cơ chế viêm tắt của các hồng cầu nhiễm KSTSR P.knowlesi cần được nghiên cứu thêm. Trong trường hợp SRAT thể não do P.falciparum, ICAM-1 cho kết quả dương tính về sự kết dính giữa các tế bào nội màng và hồng cầu nhiễm KSTSR [19].
Sự gia tăng KSTSR là một dấu hiệu để đánh giá một bệnh nhân nhiễm SRAT do P.falciparum, và đây cũng là dấu hiệu xuất hiện ở bệnh nhân SRAT do P.knowlesi [3]. Tuy nhiên, hiện tượng này lại ít phổ biến ở bệnh nhân SRAT do P.vivax. Chu kỳ phát triển 24 giờ của KSTSR P.knowlesi ở thể vô tính có thể làm gia tăng số lượng KSTSR và do đó xuất hiện các triệu chứng ác tính. Tuy nhiên, chu kỳ phát triển của P.knowlesi lại ngắn hơn so với các loài KSTSR P.falciparum và P.vivax nên hạn chế tới khả năng phát triển của KSTSR ở thể tư dưỡng trẻ (16 tư dưỡng trẻ/1 thể phân liệt so với 36/1 thể phân liệt của P.falciparum). Mặc dù có tới 24 thể tư dưỡng trẻ được hình thành từ 1 thể phân liệt trong KSTSR P.vivax, số lượng KSTSR lại ít xuất hiện ở trong các hồng cầu lưới do khả năng hạn chế về thâm nhập hồng cầu của loài KSTSR này.
Thông thường trong ca nhiễm SR do P.falciparum, KSTSR ở thể trưởng thành thường xuất hiện nhiều là do chúng có cơ chế bảo vệ khỏi quá trình lọc bỏ của lách. Tuy nhiên, KSTSR ở giai đoạn phát triển lại xuất hiện nhiều ở máu ngoại vi trong các ca nhiễm KSTSR P.knowlesi [10]. Sự phát triển của KSTSR ở bệnh nhân nhiễm P.knowlesi có thể không bị ảnh hưởng của quá trình lọc bỏ của lách như đối với các loài KSTSR không thuộc thể ẩn ở trên người.
Trong những ca tử vong do SR falciparum, sắc tố KSTSR thường xuất hiện trên các lam máu, hệ thống bạch cầu (khỏang 40%), các mô và đại thực bào. Khi đó, cũng xuất hiện những thay đổi trong hệ thống hồng cầu lưới ở cả gan và lách có liên quan tới sắc tố KSTSR; sự tập trung nhiều hồng cầu và đại thực bào cũng như một vài hiện tượng viêm nhiễm ở các mạch máu chính trong gan. Các sắc tố không cố định được xem như là dấu hiệu của quá trình tiên lượng kém của SR do falciparum [23-25] và cũng là chứng cứ để hỗ trợ quá trình ức chế miễn dịch do sắc tố, đặc biệt đối với các đại thực bào mang sắc tố và bạch cầu đơn nhân [26-28]. Chính sự phối hợp các yếu tố như tăng KSTSR, tăng sắc tố KST và tăng mức độ trầm trọng của bệnh lại giúp dễ xác định hơn trong SR do P.knowlesi so với SR do P.falciparum vốn không xác định được vì KSTSR mang sắc tố thường ở thể ẩn trong máu ngoại vi. Trong ca nhiễm SR do P.vivax, các sắc tố của KSTSR thường xuất hiện rời rạc và thường không được xem là dấu hiệu đi kèm với mức độ bệnh [29].
Trong các loài KSTSR ở người, sự dính kết tế bào được cho là chỉ có thể xảy ra đối với P.falciparum, gây nên hiện tượng KSTSR ở thể ẩn ở hầu như các thể, ngoại trừ thể tư dưỡng trẻ. Sự dính kết tế bào cũng được lưu ý trong mô tả bệnh SR và được thể hiện trên gen var (thuộc họ PfEMP-1) ở bề mặt của các tế bào hồng cầu trong máu vật chủ nhiễm bệnh [15, 30-32]. Dù chưa có nhận định chính xác, hiện tượng KSTSR ở thể ẩn cũng được tìm thấy trên ca tử vong do P.knowlesi này khi xuất hiện nhiều KSTSR mang sắc tố ở trên các lam máu của tử thi.
Chúng tôi đặt ra giả định là hiện tượng KSTSR ẩn rãi rác có thể là do sự kết dính tế bào đã nhiễm KSTSR P.knowlesi qua trung gian là các kháng nguyên bề mặt biến thể của gen SICA var của P.knowlesi (các chuổi gien thuộc họ PfEMP-1) [33, 34]. Điều quan trọng là trong ca tử vong do P.knowlesi này, không thấy hiện tượng tăng thành phần của ICAM-1, cũng như không xuất hiện kết dính do các tế bào nhiễm KSTSR nằm xen kẻ với các hồng cầu không bị nhiễm KSTSR trong các mạch máu nhỏ hơn.
SRAT thể não và hiện tượng xuất huyết cấp tính thường xuất hiện trong các ca nhiễm P.falciparum trong khi những rối loạn chức năng các cơ phận, hô hấp và chuyển hóa thường xảy ra trong ca nhiễm SR do P.knowlesi, P.vivax và các thể khác của SR do P.falciparum [3, 4, 19, 35-40]. Mặc dù các giai đoạn trưởng thành của KSTSR P.falciparum có thể xuất hiện trong máu, chúng cũng hiếm gặp và thường đi kèm với tiên lượng xấu. Trước đây, việc kiểm tra những yếu tố liên quan của một loài KSTSR với sự phát triển của các triệu chứng gây SRAT như dính kết tế bào, tăng KSTSR, SR thể não, suy chức năng các cơ quan, hô hấp và chuyển hóa, xuất huyết thường rất khó khăn nếu không có những thông tin liên quan từ các ca SRAT gây ra do các loài khác [16, 41-44]. Do đó, những ca tử vong và SRAT do P.knowlesi sẽ bổ sung những nhận định cần thiết cho cái gọi là “sinh lý bệnh học sốt rét”. Vì vậy, việc phát hành hướng dẫn chẩn đoán đặc hiệu, điều trị và quản lý SR do P.knowlesi là việc làm rất cần thiết. Một nghiên cứu lâm sàng hồi cứu tại Borneo Sarawak của Malaysia cho biết khỏang 1/10 số ca SR do P.knowlesi có các trệu chứng ác tính, và khoảng 1-2% trong số này là tử vong [4]. Những biến chứng của các ca P.knowlesi được điều trị khỏi bao gồm suy hô hấp cấp (ARDS), suy gan thận, giảm huyết áp, có hoặc không có KSTSR >100.00/µL máu. Những biến chứng trong các ca tử vong do P.knowlesi bao gồm đau bụng, suy chức năng gan-thận đi kèm với nồng độ KSTSR cao [3, 4]. P.knowlesi có khả năng sẽ phát triển thành loài KSTSR gây những triệu chứng nặng ở người hơn là động vật như hiện nay [11, 12], do đó việc giám sát chặt chẽ cộng với những hướng dẫn chi tiết về phòng chống và điều trị là rất cần thiết để có thể ngăn chận những cơn đại dịch SR bùng phát với mức độ to lớn và rầm rộ hơn.
Nguồn
- Malaria Journa- http://www.malariajournal.com/content/9/1/10
- Plasmodium knowlesi: Genome Shotgun. Wellcome Trust Sanger Institute.
- Natural acquired Plasmodium knowlesi malaria in human, Thailand. Emerging Infectious Diseases, Dec, 2004 by Somchai Jongwutiwes, Chaturong Putaporntip, Takuya Iwasaki, Tetsutaro Sata, Hiroji Kanbara
- Plasmodium Knowlesi Malaria. General medicine community. http://www.wellsphere.com/general-medicine-article/plasmodium-knowlesi-nbsp-malaria/717221
- Plasmodium knowlesi tại Viêt Nam- Phùng Đức Thuận - Khoa SHPT và MD-Viện Sốt rét-KST-CT Tp. Hồ Chí Minh
Tài liệu tham khảo
1.Snow RW, Guerra CA, Mutheu JJ, Hay SI: Int ernational funding for malaria control in relat ion to populations at risk of stable Plasmodium falciparumtransmission . Plos Med 2008, 5 :e142.
2.World Health Organization, World Malaria Report [ http://www.who.int/malaria/wmr2008/ ]
3.Cox-Singh J, Davis TM, Lee KS, Shamsul SS, Matusop A, Ratnam S, Rahman HA, Conway DJ, Singh B: Plasmodium knowlesi malaria in humans is widely distributed and potentially life threatening . Clin Infect Dis 2008, 46 :165-171.
4.Daneshvar C, Davis C, Cox-Singh J, Rafa'ee M, Zakaria S, Divis P, Singh B: Clinical and laboratory features of human Plasmodium falciparum infections.Clin Infect Dis 2009, 49 :852-860.
5.Coatney GR, Collins WE, Warren M, Contacos PG: The primate malarias. Bethesd a, MD: U.S. Department of Health, Education and Welfare, NationalInstitutes of Health; 1971.
6.Lan gho rne J, Cohen S: Plasmodium knowlesiin the marmoset (Callithrix jacchus ) . Parasitology 1979, 78 :67-76.
7.Ozwara H, Lan germans JA, Maamun J, Farah IO, Yole DS, Mwenda JM, Weiler H, Thomas AW: Experimental infection of the olive baboon ( Papio anubis ) with Plasmodium knowlesi : severe disease accompanied by cerebral involvement . Am J Trop Med Hyg 2003, 69 :188-194.
8.Miller LH, Fr emount HN, Luse SA: Deep vascular schizogony of Plasmodium knowlesi in Macaca mulatta . Distribution in organs and ultrastructure of parasitized red cells . Am J Trop Med Hyg 1971, 20 :816-824.
9.Singh B, Kim Sung L, Matusop A, Radhakrishnan A, Shamsul SS, Cox-Singh J, Thomas A, Conway DJ: A large focus of naturally acquired Plasmodium knowlesi infections in human beings . Lancet 2004, 363 (9414):1017-1024.
10.Lee KS, Cox-Singh J, Singh B: Morphological features and differential counts of Plasmodium knowlesiparasites in naturally acquired human inf ections. MalarJ2009: 8 :73.
11.Cox-Singh J, Singh B: Knowlesi malaria: newly emergent and of public health importance?Trends Parasitol 2008, 24 :406-410.
12.McCutchan FE: Ismonkey malaria fro m Borneo an emerging human disease?Future Microbiol 2008, 3 :115 - 118.
13.Newton CR, Krishna S: Severe falciparummalaria in children: current understanding of pathophysiology and supportive treatment . Pharmacol Ther 1998, 79 :1-53.
14.Taylor TE, Fu WJ, Carr RA, Whitten RO, Mueller JS, Fosiko NG, Lewallen S, Liomba NG, Molyn eux ME: Differentiating the pathologies of cerebral malaria by postmortem parasite counts . Nat Med 2004, 10 :143-145.
15.Turner GD, Morrison H, Jones M, Davis TM, Looareesu wan S, Buley ID, Gatter KC, Newbold CI,Pukritayakamee S, Nagachinta B, White NJ, Berendt AR: An immunohistochemical study of the pathology of fatal malaria. Evidence for widespread endothelial activation and a potential role f or intercellular adhesion molecule-1 in cerebral sequestration . Am J Path ol 1994, 145 :1057-1069.
16.White N: Malaria pathophysiology . In: Malaria: Parasite Biology, Pathogenesis and Protection.Edited by ShermanIW. Washington DC: ASM Press; 1998: 371 - 385.
17.Genrich GL,Guarn er J, Paddock CD, Shieh WJ, Greer PW, Barnwell JW, Zaki SR: Fatal malaria infection in travelers: novel immunohistochemical assays for the detection of P lasmodium falciparumin tissues and implications for pathogenesis . Am J Trop Med Hyg 2007, 76 :251- 259.
18.Lucas S: The autopsy pathology of sepsis-related death.Current Diagnostic Pathology 2007, 13 :375-388.
19.Anstey NM, Handojo T, Pain MC, Kenangalem E, Tjitra E, Price RN, Maguire GP: Lung injury in vivax malaria: pathophysiological evidence for pulmonary vascular sequestration and posttreatment alveolar-capillary inflammation.J Inf Dis 2007, 195 :589-596.
20.Beg MA, Khan R, Baig SM, Gulzar Z, Hussain R, Smego RA, Jr.: Cerebral involvement in benign tertian malaria . Am J Trop Med Hyg 2002, 67 (3):230-232.
21.Genton B, D'Acremont V, Rare L, Baea K, Reeder JC, Alpers MP, Muller I: Plasmodium vivaxand mixed infections are associated with severe malaria in children: a prospective cohort study from Papua New Guinea. Plos Med 2008,5 :e127.
22.WHO: Severe falciparummalaria. World Health Organizsation, Communicable Diseases Cluster.Trans R Soc Trop Med and Hyg 2000, 94 Suppl 1 :S1 - 90.
23.Kremsner PG, Valim C, Missinou MA, Olola C, Krishna S, Issifou S, Kombila M, Bwan aisa L, Mithwani S, Newton CR, Agbenyega T, Pinder M, Bojan g K, WypijD, Taylo r T: Prognostic value of circulating pigmented cells in african African children with malaria . J Inf Dis 2009, 199 :142-150.
24.LykeKE, Diallo DA, Dicko A, Kone A, Coulibaly D, Guindo A, Cissoko Y, SangareL, Coulibaly S, Dakouo B, Taylor T, Doumbo OK, Plowe C: Association ofintraleukocytic Plasmodiumfalciparum malaria pigment with disease severity, clinical manifestations, and prognosis in severe malaria. Am J Trop Med Hyg 2003, 69 :253-259.
25.Nguyen PH, Day N, Pram TD, Ferguson DJ, White NJ: Intraleucocytic malaria pigment and prognosis in severe malaria. Trans R Soc Trop Med Hyg1995, 89 :200-204.
26.Awandare GA,Ouma Y,Ouma C, Were T, Otieno R, Keller CC, Davenport GC, Hittner JB, Vulule J, Fer rell R, ong’echa JM, Perkins D: Role of monocyte-acquired hemozoin in suppression of macrophage migration inhibitory factor in children with severe malarial anemia . Infect Immun 2007, 75 :201-210.
27.Carney CK, Schrimpe AC, Halfpenn y K, Harry RS, Miller CM, Broncel M, Sewell SL, Schaff JE, Deol R, Carter MD, Wright DW:The basis of the immunomodulatory activity of malaria pigment (hemozoin). J Biol Inorg Chem 2006, 11 :917-929.
28.Deshpande P, Shastry P: Modulation of cytokine profiles by malaria pigment--hemozoin: role of IL-10 in suppression of proliferative responses of mitogen stimulated human PBMC . Cytokine 2004, 28 :205-213.
29.McGready R, Davison BB, Stepniewska K, Cho T, Shee H, Brockman A, Udomsangpetch R, Looareesuwan S, White NJ, Meshnick SR, Nosten F: The effects of Plasmodium falciparumand P. vivaxinfections on placental histopathology in an area of low malaria transmission . Am J Trop Med Hyg 2004, 70 :398-407.
30.Su XZ, Heatwole VM, Wertheimer SP, Guinet F, Herrfeldt JA, Peterson DS, Ravetch JA, Wellems TE: The large diverse gene family var encodes proteins involved in cytoadherence and antigenic variation of Plasmodium falciparum -infected erythrocy tes . Cell 1995, 82 :89-100.
31.Flick K, Chen Q: var genes, PfEMP1 and the human host . Mol Biochem Parasitol 2004, 134 :3-9.
32.Ockenhouse CF, Tegoshi T, Maeno Y, BenjaminC, Ho M, Kan KE, Thway Y, Win K, Aikawa M, LobbRR: Human vascular endothelial cell adhesion receptors for Plasmodium falciparum -infected erythrocyt es: roles for endothelial leukocyte adhesion molecule 1 and vascular cell adhesion molecule 1. J Exp Med 1992, 176 :1183-1189.
33.Pain A, Bohme U, BerryAE, Mungall K, Finn RD, Jackson AP, Mourier T, Mistry J, Pasini EM, Aslett MA , Balasub rammaniam S, Borgwardt K, Brooks K, Carret C, Carver TJ, Cherevach I, Chillingworth T, Clark TG, Galinski MR, Hall N, Harper D, Harris D, Hau ser H, Ivens A, Janssen CS, Keane T, Larke N, Lapp S, Marti M, Moule S, Meyer IM,Ormond D, Peters N, Sanders M, Sanders S, Sar geant TJ, Simmonds M, Smith F, Squares R, Thurston S, Tivey AR, Walker D, White B, Zuiderwijk E, Churcher C, Quail MA, Cowman AF, Turner CMR, Rajandream MA, Kocken CHM, Thomas AW, Newbold CI, Barrell BG, Berriman M: Thegenome ofthe simian and human malaria parasite Plasmodium knowlesi . Nature 2008, 455 :799-803.
34.Barnwell JW, Howard RJ, Miller LH: Altred expression of Plasmodium knowlesi variant antigen on the erythrocyte membrane in splenectomized rhesus monkeys . JImmunol 1982, 128 :224-226.
35.Price L, Planche T, Rayn er C, Krishna S:Acute respiratory distress syndrome in Plasmodium vivaxmalaria: case report and review of the literature . Trans R Soc Trop Med Hyg 2007, 101 :655-659.
36.Coltel N, Combes V, Hunt NH, Grau GE: Cerebral malaria-a neurovascular pathology with many riddles still to be solved. Curr Neurovasc Res 2004, 1 :91-110.
37.Deitsch KW, Hviid L: Variant surface antigens, virulence genes and the pathogenesis of malaria .Trends Parasitol 2004, 20 :562-566.
38.Idro R, Jenkins NE, Newton CR: Pathogenesis, clinical features, and neurological outcome ofcerebral malaria . Lancet Neurol 2005, 4 :827-840.
39.Sun G, Chang WL, Li J, Berney SM, Kimpel D, van der Heyde HC: Inhibition of platelet adherence to brain microvasculature protects against severe Plasmodium berghei malaria . Infect Immun 2003, 71 :6553-6561.
40.Taoufiq Z, Gay F, Balvanyos J, Ciceron L, Tefit M, Lechat P, Mazier D:Rhokinase inhibition in severemalaria: thwarting parasite-induced collateral damage to endothelia . J Inf Dis 2008, 197 :1062-1073.
41.Beeson JG, Brown GV: Pathogenesis ofPlasmodium falciparum malaria: the roles ofparasite adhesion and antigenic variation. Cell Mol Life Sci 2002, 59 :258-271.
42.Jensen AT, Magistrado P, Sharp S, Joergensen L,Lavstsen T, Chiucchiuini A, Salanti A, Vestergaard LS, Lusingu JP, Hermsen R, Sauerwein R, Chritensen J, Nielsen MA, Hviid l, Sutherland C, Staalsoe T, Theander TG: Plasmodium falciparum associated with severe childhood malaria preferentially expresses PfEMP1 encoded by group A var genes . J Exp Med 2004, 199 :1179-1190.
43.Newton CR, Taylor TE,Whitten RO: Pathophysiology of fatal falciparum malaria in Af rican children . Am J Trop Med Hyg 1998, 58 :673-683.
44.Clark IA, Alleva LM: Is human malarial coma caused, or merely deepened, by sequestration?Trends Parasitol 2009, 25 :314-318.